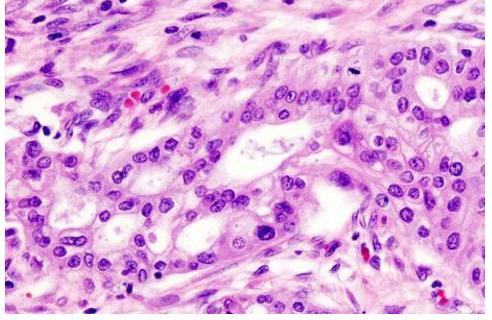
100亿活性乳酸菌,灭活乳酸杆菌

爱美是天性
但是很多人常常会忽略的一个细节
那就是关于私密的护理

与身体其他部位类似
随着年龄增大,尤其是经过分娩
女性私密处也会经历逐渐衰老 的自然进程
有时候私密处的衰老
比面部还要更早、更快
更影响身心的健康

/ 这里紧致,和脸一样重要 /
私密的健康变化
当然从私密地带来发现
一般分为外阴内阴
很多人的盲区在
私密护理只是普通的清洗
和贴身衣物的换洗

然而这只是其中最小
最微不足道的一分部
○ 外阴
色素沉着相对加重
开始逐渐 出现干皱、萎缩
甚至容易 出现干燥、灼热
瘙痒等不适自主症状

○ 内阴
会出现上皮变薄,皱壁减少
上皮层血流分布和内分泌物减少
糖原合成减少
阴道内环境和ph值发生变化
容易产生炎症感染
阴道松弛、弹性和收缩力下降
严重者可能会出现
外阴阴道萎缩松弛综合症

盆底肌和阴道的松弛
对尿道的支撑力减弱
甚至可能引起压力性尿*禁失**
咳嗽、打喷嚏、哈哈大笑
跑步等腹压增大时
尿液不受控制的流出
最关键的是
体内激素问题
雌激素可以维持体内纤维的张力和弹性
各种原因导致的雌激素水平的下降
也会引起和加重私密处的萎缩和松弛情况
/ 如何预防、改善*处私**老化 /
随着女性私密护理的觉醒
市场上的护理用品也如雨后春笋般冒出
但毕竟涉及到私密处
对产品的选择更加不能盲目
如何选择安全且有用的私密产品

在抗(抑)菌剂中
对微生物具有杀灭或抑制作用的物质
其中有效成分是
一款私密护理产品的核心秘籍
而 微生态修护晶粉主要
核心成灭活益生菌

灭活益生菌是一种
最 新型安全性更高 的
且能有效替代抗生素治疗
细菌性阴道疾病的工具
可以用于生产阴道功能性配方栓剂
既可以引起有益的免疫反应
还可以下调不良免疫反应
炎症反应和过敏反应

既可以调节非特异性免疫功能
增强粘膜的屏障作用
产生细胞因子
维持阴道正常的酸性环境
还可以 调节特异性免疫功能
刺激免疫细胞的增殖分化

以灭活益生菌为原料
超小分子迅速渗透真皮层
妇科炎症引起的
阴道粘膜损伤受损部位
100亿颗益生菌含量
促进*处私**上皮细胞再生长
增强阴道内皮细胞间隙
帮助阴道内皮撕裂伤口愈合
即使生产或者外伤导致阴道撕裂
也有极好的修复效果
让女性的生殖系统恢复健康状态

菌粉和灭活技术的融合
能高效抑制
*处私**衰老 的问题
制成粉
保留成分最大 无菌、安全高效

两*生活性**中
是最容易一不小心造成问题
而随着年龄增长
*处私**的衰老
性敏感度低:*生活性**就像是完成任务
完全不能投入其中

还有水解胎盘提取物
是从怀孕的母山羊胎盘中
提取出的一种生物活性物质
是一种多肽蛋白质物质

羊胎盘中所含有的羊胎素
对于肌肤老化具有很好的缓解作用
能够 减少细纹
让肌肤更加 柔嫩、光滑、细腻有光泽
每只都是独立包装
取用简单、卫生
可以直接与精华混合使用
无需二次冲洗

晶粉作为私密护理的“新大门”
成分温和不刺激
与以往的相对比见效更快
能促进女性雌性激素分泌
维持女性荷尔蒙分泌水平
修复 受损弹性纤维细胞
增强阴道内平滑肌的弹性

增加阴道内粘膜褶皱
使阴道变得 紧窄有力
让*处私** 恢复紧致水润
为*福性**生活“紧”上添花
其实私密处跟脸一样
会随着岁月流失水分及胶原蛋白
所谓*处私**老化
通常是指女子随着年龄的增长
出现阴道松弛的一种生理状况
所以日常的护理各位仙女们
一定要记得多多爱护哟~~